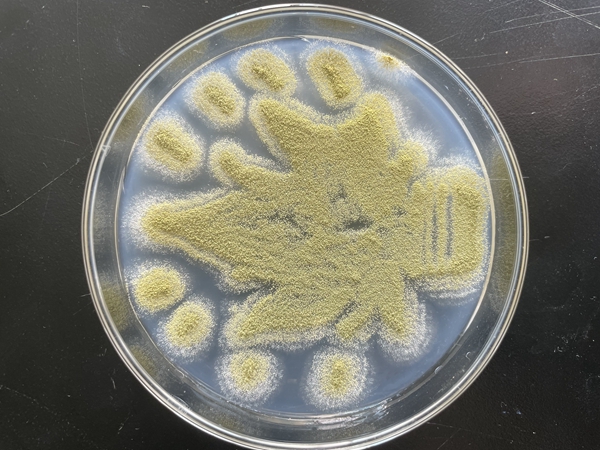
QQ鍥剧墖20221202172534_鍓

11月28日,由湖北省科学技术协会联合多所高校主办的湖北省第一届微生物培养皿艺术设计大赛顺利落下帷幕。我校生物与制药工程学院组织40支队伍参赛,荣获优秀奖4项。我校同时荣获“优秀组织单位”荣誉称号。

本届比赛以“科学探索‘微’之美,青春献礼二十大”为主题,要求参赛团队依据大赛主题,通过微生物培养技术在培养皿上进行艺术创作,使在培养基上生长的、表达不同颜色的微生物组成各种各样积极向上的正能量图案;同时需对相关微生物的种类、生长情况、颜色情况等进行科学研究,以更好地利用微生物进行艺术创作,形成创意细菌画作品。大赛主要考察参赛团队的微生物基本知识、基本实验操作能力和研究能力、艺术设计和创造能力等。全省22所高校近千支队伍共提交了839份参赛作品。

比赛启动以来,生物与制药工程学院积极动员师生参与。生物制药系主任翁德会帮助寻找优质菌种,张晓雯、王敬、左成等教师悉心指导。各参赛小组成员根据自己的创意,分别选用白色大肠杆菌,黄色细菌,黑色、绿色的霉菌,红色的酵母菌等菌种进行实验。为了呈现更完美的设计作品,师生们利用课余、周末和休息时间,反复对参赛作品及设计理念进行修改优化。由于微生物作画的特殊性,绘画设计过程中需要反复实验反复试错。师生们本着科学的严谨态度,默契配合,反复钻研,通过探索微生物最适生长条件,如培养基成分及比例、培养温度、培养湿度、培养时间等,以及不同作画工具、不同菌液浓度对绘画结果的影响,确定最佳实验方案,最终呈现各具特色的微生物画作品。
赛后,实验教师张晓雯积极吸取竞赛经验,在教研室活动中分享“竞赛与实验教学结合的探索”为主题的教研会议,分析赛教融合优势价值,从不同专业角度深度剖析“以问题为导向的实验教学课程改革方向”。
实验中心主任刘桂艳指出,本次比赛充分发挥了学院专业特色,“以菌为心,寄情于皿”,将党的二十大精神充分融入专业知识教育中,进一步培养了学生创新创业精神和团队合作意识。学院将继续以此为契机,将竞赛与实验课程学习、技能训练紧密结合,将学、练、赛与教融为一体,提高学生的专业技术技能、创新意识,培养生物制药类“新工科”人才。







